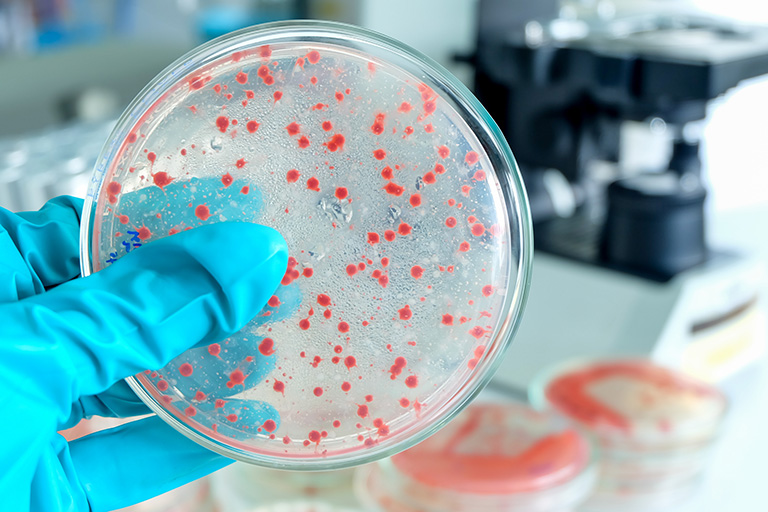
Microbiology

Servizi
Ricerca >>
Key Stages of Development
Our network of laboratories offers a full range of services to retailers and cosmetic manufacturers from raw materials suppliers to finished products producers. Each lab counts with highly qualified teams dedicated to develop and implement test protocols, quality assurance guaranteeing reliability, reproducibility and traceability of results and high-tech equipment.